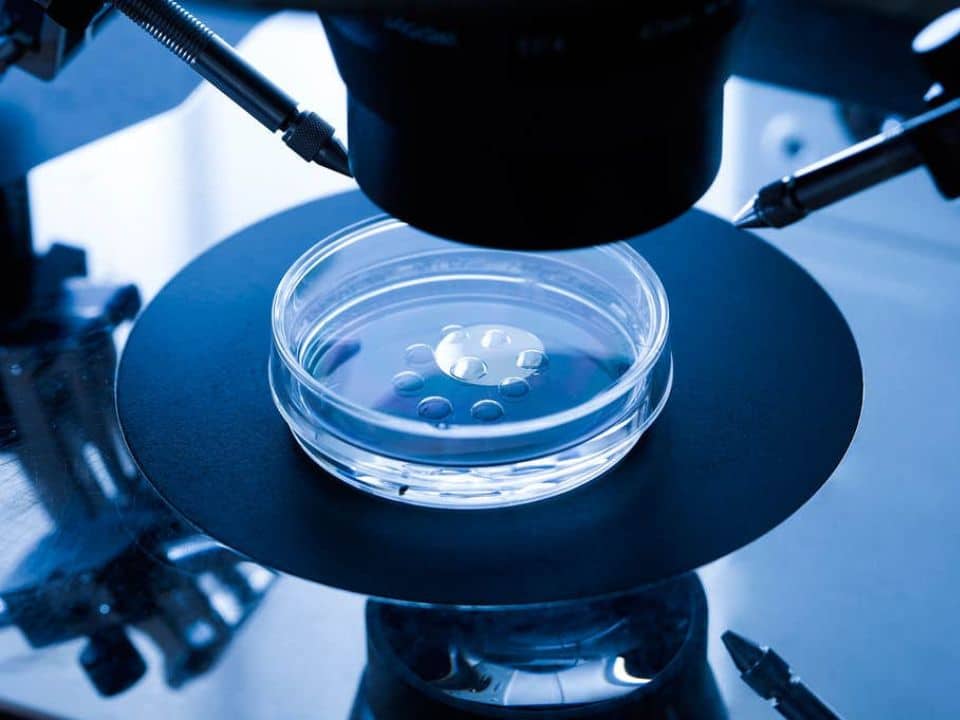
in-vitro-fertilization-in-laboratory-using-picsi-technique

¿Sabías que la Fertilización In Vitro (FIV) tiene algunas variantes con respecto a la técnica para llevarla a cabo? Esto de acuerdo con el diagnóstico específico de cada persona, variantes que sirven para aumentar las probabilidades de éxito de tener un bebé en casa.
Las diferentes variantes que existen de la técnica de FIV son las siguientes:
- Fertilización In Vitro Convencional
- Fertilización In Vitro mediante técnica ICSI
- Fertilización In Vitro mediante técnica PICSI
En este artículo te explicaremos lo que necesitas saber acerca de la técnica PICSI o Inyección Intracitoplasmática Fisiológica de Espermatozoides, para lograr a tu bebé.
PICSI: la técnica más avanzada en tratamientos de Reproducción Asistida
La técnica PICSI hace posible seleccionar un único espermatozoide ideal, con base en su habilidad para unirse al ácido hialurónico, una sustancia muy similar a la que rodea al óvulo, y que se utiliza para medir la capacidad de adherencia de los espermatozoides.
Los espermatozoides seleccionados de esta forma son de mejor calidad que aquellos seleccionados de forma convencional mediante la observación de andrólogos expertos.
La selección de espermatozoides mediante esta técnica de Fecundación In Vitro, permite obtener mejores tasas de fecundación y reduce las probabilidades de aborto, resultando en una mayor probabilidad de lograr un bebé en casa.
¿Cuándo se recomienda realizar una FIV por técnica PICSI?
Cuando se presentan casos en los que la FIV mediante la Microinyección Intracitoplasmática de Espermatozoides (ICSI) no se obtienen los resultados deseados, los especialistas en fertilidad recomiendan la Fecundación In Vitro mediante PICSI, que fue diseñado principalmente para mejorar la práctica de ICSI.
La técnica PICSI se recomienda específicamente en casos complicados de infertilidad masculina, en los que los espermatozoides son muy escasos o tienen problemas de movilidad o en su forma.
¿Cómo se lleva a cabo una FIV mediante PICSI?

El proceso inicia al preparar una placa de cultivo estéril con tres micropuntos de hidrogel de ácido hialurónico en el fondo interior.
Dicha placa cuenta con tres líneas de localización en relieve en el fondo exterior, con el fin de ayudar al especialista en reproducción a encontrar los micropuntos.
Una vez que los espermatozoides se adhieren al ácido hialurónico, se selecciona el más apto para la fecundación y se inyecta directamente en el óvulo.
Posteriormente, se continúa con el procedimiento usual de FIV para trasladar al útero el embrión resultante, y que este pueda continuar su desarrollo durante los 9 meses siguientes.
¿Te interesa la técnica PICSI de Fecundación In Vitro para tener a tu bebé?
En Ingenes contamos con el equipo y tecnología necesarios para realizar las técnicas de FIV convencional, ICSI y PICSI, en caso de ser requeridas en cualquiera de nuestros Programas Multiciclo de FIV, mismos que hemos perfeccionado incrementar las posibilidades de tener un bebé en casa hasta un 96%.
¿Te interesa conocer cuál es el tratamiento ideal para ti? Responde este cuestionario y nuestros expertos en fertilidad te indicarán la mejor opción para tener a tu bebé en el menor tiempo posible.